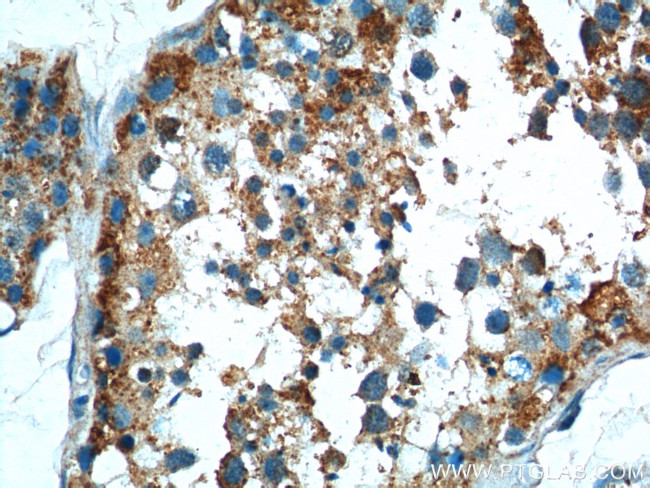
TICAM1 Antibody in Immunohistochemistry (Paraffin) (IHC (P))
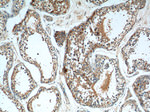
TICAM1 Antibody in Immunohistochemistry (Paraffin) (IHC (P))
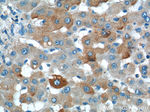
TICAM1 Antibody in Immunohistochemistry (Paraffin) (IHC (P))

Search
Proteintech
TICAM1 Polyclonal Antibody
{{$productOrderCtrl.translations['antibody.pdp.commerceCard.promotion.promotions']}}
{{$productOrderCtrl.translations['antibody.pdp.commerceCard.promotion.viewpromo']}}
{{$productOrderCtrl.translations['antibody.pdp.commerceCard.promotion.promocode']}}: {{promo.promoCode}} {{promo.promoTitle}} {{promo.promoDescription}}. {{$productOrderCtrl.translations['antibody.pdp.commerceCard.promotion.learnmore']}}
产品信息
23288-1-AP
种属反应
已发表种属
宿主/亚型
分类
类型
抗原
偶联物
形式
浓度
规格
纯化类型
保存液
内含物
保存条件
运输条件
产品详细信息
Immunogen sequence: LDEHSQIFA RKVANTFKPH RLQARKAMWR KEQDTRALRE QSQHLDGERM QAAALNAAYS AYLQSYLSYQ AQMEQLQVAF GSHMSFGTGA PYGARMPFGG QVPLGAPPPF PTWPGCPQPP PLHAWQAGTP PPPSPQPAAF PQSLPFPQSP AFPTASPAPP QSPGLQPLII HHAQMVQLGL NNHMWNQRGS QAPEDKTQEA E (513-712 aa encoded by BC035331)
靶标信息
Involved in innate immunity against invading pathogens. Adapter used by TLR3 and TLR4 (through TICAM2) to mediate NF-kappa-B and interferon-regulatory factor (IRF) activation, and to induce apoptosis. Ligand binding to these receptors results in TRIF recruitment through its TIR domain. Distinct protein-interaction motifs allow recruitment of the effector proteins TBK1, TRAF6 and RIPK1, which in turn, lead to the activation of transcription factors IRF3 and IRF7, NF-kappa-B and FADD respectively.
仅用于科研。不用于诊断过程。未经明确授权不得转售。
生物信息学
蛋白别名: hCG_39321; HSD34; MyD88-3; Proline-rich, vinculin and TIR domain-containing protein B; Putative NF-kappa-B-activating protein 502H; RNF36; TI; TICAM-1; TIR domain containing adaptor inducing interferon-beta; TIR domain-containing adapter molecule 1; TIR domain-containing adapter protein inducing IFN-beta; toll like receptor adaptor molecule 1; Toll-interleukin-1 receptor domain-containing adapter protein inducing interferon beta
基因别名: IIAE6; MyD88-3; PRVTIRB; TICAM-1; TICAM1; TRIF
UniProt ID: (Human) Q8IUC6
Entrez Gene ID: (Human) 148022